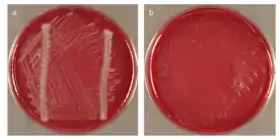

Chloroflexi
Chloroflexi sau Chlorobacteria este o încrengătură ce conține specii de bacterii diverse. Unele specii sunt termofile aerobe, altele sunt fototrofe anoxigenice (bacterii verzi). Aceste specii sunt bacterii Gram-negative în colorația Gram.[1]
| Chloroflexi | |
|---|---|
![]() | |
| Chloroflexus | |
| Clasificare științifică | |
| Domeniu: | Bacteria |
| (neclasificat): | Terrabacteria |
| Încrengătură: | Chloroflexi (Garrity and Holt 2002) Hugenholtz and Stackebrandt 2004 |
| Clase | |
| |
| Sinonime | |
| |
Note
- Sutcliffe, I. C. (). „A phylum level perspective on bacterial cell envelope architecture”. Trends in Microbiology. 18 (10): 464–470. doi:10.1016/j.tim.2010.06.005. PMID 20637628.
This article is issued from Wikipedia. The text is licensed under Creative Commons - Attribution - Sharealike. Additional terms may apply for the media files.